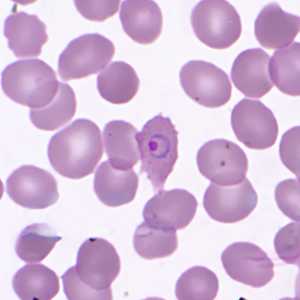
Case359_D

Case #359 - November, 2013
A 19-year-old female presented to the emergency room with fever, chills, and nausea on a 48-hour cycle. She had travel history to the Bahamas and Tanzania, but has not been abroad for nearly nine months. The patient reported that she was diagnosed with Plasmodium falciparum malaria five months prior to the current symptoms and treated accordingly. Blood films were prepared, stained with Wright-Giemsa, and examined by the attending pathologist. Images were captured and sent to the DPDx Team for diagnostic assistance. Figures A-F were among the images sent. What is your diagnosis? Based on what criteria?

Figure A

Figure B

Figure C
Figure D

Figiure E

Figure F
Case Answer
This was a case of malaria caused by Plasmodium ovale. Diagnostic morphologic features included:
- elongation and fimbriation of infected RBCs (Figures A-E).
- Schüffner's stippling (Figures C-F).
- rings with sturdy cytoplasm and a single, large chromatin dot (Figures A-E).
- slightly-enlarged, rounded gametocytes with coarse pigment (Figure F).
Given the time delay between international travel and the current diagnosis, this case probably represented a relapse. It is uncertain if the earlier diagnosis of P. falciparum represented a misidentification or a mixed infection whereby the P. ovale was below the detection level for morphologic analysis.
More on: Malaria
Images presented in the monthly case studies are from specimens submitted for diagnosis or archiving. On rare occasions, clinical histories given may be partly fictitious.
DPDx is an education resource designed for health professionals and laboratory scientists. For an overview including prevention and control visit www.cdc.gov/parasites/.
- Page last reviewed: August 24, 2016
- Page last updated: August 24, 2016
- Content source:
- Global Health – Division of Parasitic Diseases and Malaria
- Notice: Linking to a non-federal site does not constitute an endorsement by HHS, CDC or any of its employees of the sponsors or the information and products presented on the site.
- Maintained By:


 ShareCompartir
ShareCompartir